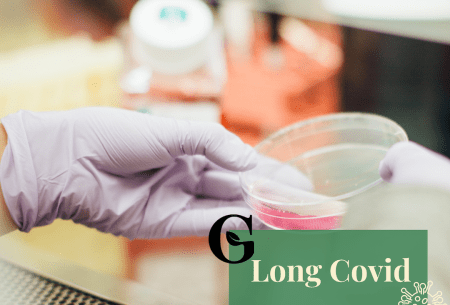
petri dish with text reading 'long covid'

The latest fad-free science on nutrition, gut health and beyond. Our qualified experts, including our team of specialist dietitians from The Gut Health Clinic, share cutting-edge research, evidence-based strategies and dispel myths and misconceptions. We want you to be empowered to take control of your own health and happiness.
Learn about nutrition and gut health

Find an article

By The Gut Health Doctor Team
Coconut oil: superfood or superfad?

By The Gut Health Doctor Team
HIIT workouts for cognitive function

By The Gut Health Doctor Team
Optimising gut health

By The Gut Health Doctor Team
Do detoxes work?

By The Gut Health Doctor Team
Organic vs non-organic: is there a benefit to our gut and overall health?

By The Gut Health Doctor Team
Empowering women in science

By The Gut Health Doctor Team
Is chocolate really an aphrodisiac?
By The Gut Health Doctor Team
Long-Covid: explained

By The Gut Health Doctor Team










